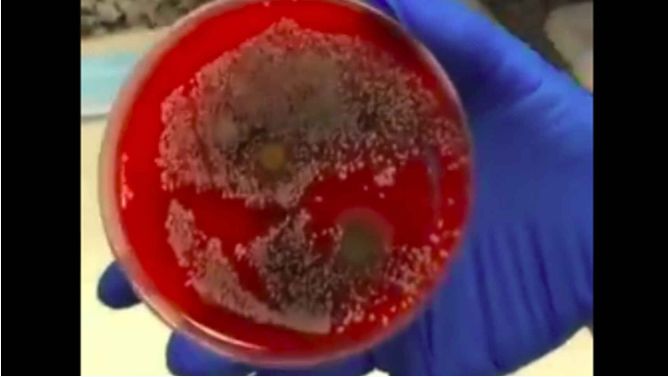

Sabemos de sobra que el uso de la mascarilla es obligatorio en todo momento. Y precisamente porque su uso es continuado durante las 24 horas del día, también debemos saber cada cuanto es recomendable cambiarla o lavarla.
Una cuestión que no queda del todo claro, sobre todo por los diferentes tipos de mascarillas que hay en el mercado. Los tejidos y las diferentes telas que se emplean dependen también del entorno en el que nos encontramos, seamos o no sanitarios, existen unas pautas generalizadas que debemos conocer, el tipo de mascarillas que son mejor dependiendo del uso, el número de horas que se lleva puesta, y lo que puede pasarte si no renuevas en tiempo y forma tu mascarilla.
4¿Qué pasa cuando reutilizamos una mascarilla que no sirve?
La doctora María Luisa García Alonso, farmacéutica y directora del laboratorio EAAC (Estudios Analíticos Aplicados a la Clínica), ha explicado qué es lo que sucede cada vez que reutilizamos la mascarilla o nos ponemos una que ya hemos usado antes. Y el resultado desde su laboratorio fue muy gráfico, pues se mostraron unas placas infestadas de distintos hongos y bacterias.